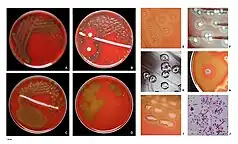

Streptococcus pneumoniae
| Streptococcus pneumoniae | |
|---|---|
![]() | |
| S. pneumoniae in spinal fluid. FA stain (digitally colored). | |
| Scientific classification | |
| Domain: | Bacteria |
| Phylum: | Bacillota |
| Class: | Bacilli |
| Order: | Lactobacillales |
| Family: | Streptococcaceae |
| Genus: | Streptococcus |
| Species: | S. pneumoniae |
| Binomial name | |
| Streptococcus pneumoniae (Klein 1884) Chester 1901 | |
Streptococcus pneumoniae, or pneumococcus, is a Gram-positive, spherical bacteria, alpha-hemolytic member of the genus Streptococcus.[1] S. pneumoniae cells are usually found in pairs (diplococci) and do not form spores and are non motile.[2] As a significant human pathogenic bacterium S. pneumoniae was recognized as a major cause of pneumonia in the late 19th century, and is the subject of many humoral immunity studies.
Streptococcus pneumoniae resides asymptomatically in healthy carriers typically colonizing the respiratory tract, sinuses, and nasal cavity. However, in susceptible individuals with weaker immune systems, such as the elderly and young children, the bacterium may become pathogenic and spread to other locations to cause disease. It spreads by direct person-to-person contact via respiratory droplets and by auto inoculation in persons carrying the bacteria in their upper respiratory tracts.[3] It can be a cause of neonatal infections.[4]
Streptococcus pneumoniae is the main cause of community acquired pneumonia and meningitis in children and the elderly,[5] and of sepsis in those infected with HIV. The organism also causes many types of pneumococcal infections other than pneumonia. These invasive pneumococcal diseases include bronchitis, rhinitis, acute sinusitis, otitis media, conjunctivitis, meningitis, sepsis, osteomyelitis, septic arthritis, endocarditis, peritonitis, pericarditis, cellulitis, and brain abscess.[6]
Streptococcus pneumoniae can be differentiated from the viridans streptococci, some of which are also alpha-hemolytic, using an optochin test, as S. pneumoniae is optochin-sensitive. S. pneumoniae can also be distinguished based on its sensitivity to lysis by bile, the so-called "bile solubility test". The encapsulated, Gram-positive, coccoid bacteria have a distinctive morphology on Gram stain, lancet-shaped diplococci. They have a polysaccharide capsule that acts as a virulence factor for the organism; more than 100 different serotypes are known, and these types differ in virulence, prevalence, and extent of drug resistance.
The capsular polysaccharide (CPS) serves as a critical defense mechanism against the host immune system. It composes the outermost layer of encapsulated strains of S. pneumoniae and is commonly attached to the peptidoglycan of the cell wall.[7] It consists of a viscous substance derived from a high-molecular-weight polymer composed of repeating oligosaccharide units linked by covalent bonds to the cell wall. The virulence and invasiveness of various strains of S. pneumoniae vary according to their serotypes, determined by their chemical composition and the quantity of CPS they produce. Variations among different S. pneumoniae strains significantly influence pathogenesis, determining bacterial survival and likelihood of causing invasive disease.[8] Additionally, the CPS inhibits phagocytosis by preventing granulocytes' access to the cell wall.[9]
History
In 1881, the organism, known later in 1886 as the pneumococcus[10] for its role as a cause of pneumonia, was first isolated simultaneously and independently by the U.S. Army physician George Sternberg[11] and the French chemist Louis Pasteur.[12]
The organism was termed Diplococcus pneumoniae from 1920[13] because of its characteristic appearance in Gram-stained sputum. It was renamed Streptococcus pneumoniae in 1974 because it was very similar to streptococci.[10][14]
Streptococcus pneumoniae played a central role in demonstrating that genetic material consists of DNA. In 1928, Frederick Griffith demonstrated transformation of life turning harmless pneumococcus into a lethal form by co-inoculating the live pneumococci into a mouse along with heat-killed virulent pneumococci.[15] In 1944, Oswald Avery, Colin MacLeod, and Maclyn McCarty demonstrated that the transforming factor in Griffith's experiment was not protein, as was widely believed at the time, but DNA.[16] Avery's work marked the birth of the molecular era of genetics.[17]
Genetics
The genome of S. pneumoniae is a closed, circular DNA structure that contains between 2.0 and 2.1 million base pairs depending on the strain. It has a core set of 1553 genes, plus 154 genes in its virulome, which contribute to virulence and 176 genes that maintain a noninvasive phenotype. Genetic information can vary up to 10% between strains.[18] The pneumococcal genome is known to contain a large and diverse repertoire of antimicrobial peptides, including 11 different lantibiotics.[19]
Transformation
Natural bacterial transformation involves the transfer of DNA from one bacterium to another through the surrounding medium. Transformation is a complex developmental process requiring energy and is dependent on expression of numerous genes. In S. pneumoniae, at least 23 genes are required for transformation. For a bacterium to bind, take up, and recombine exogenous DNA into its chromosome, it must enter a special physiological state called competence.[20] Competence in S. pneumoniae is induced by DNA-damaging agents such as mitomycin C, fluoroquinolone antibiotics (norfloxacin, levofloxacin and moxifloxacin), and topoisomerase inhibitors.[21] Transformation protects S. pneumoniae against the bactericidal effect of mitomycin C.[22] Michod et al.[23] summarized evidence that induction of competence in S. pneumoniae is associated with increased resistance to oxidative stress and increased expression of the RecA protein, a key component of the recombinational repair machinery for removing DNA damage. On the basis of these findings, they suggested that transformation is an adaptation for repairing oxidative DNA damage. S. pneumoniae infection stimulates polymorphonuclear leukocytes (granulocytes) to produce an oxidative burst that is potentially lethal to the bacteria. The ability of S. pneumoniae to repair oxidative DNA damage in its genome caused by this host defense likely contributes to the pathogen's virulence. Consistent with this premise, Li et al.[24] reported that, among different highly transformable S. pneumoniae isolates, nasal colonization fitness and virulence (lung infectivity) depend on an intact competence system.
Infection
Streptococcus pneumoniae is part of the normal upper respiratory tract flora. As with many natural flora, it can become pathogenic under the right conditions, typically when the immune system of the host is suppressed. Invasins, such as pneumolysin, an antiphagocytic capsule, various adhesins, and immunogenic cell wall components are all major virulence factors. After S. pneumoniae colonizes the air sacs of the lungs, the body responds by stimulating the inflammatory response, causing plasma, blood, and white blood cells to fill the alveoli. This condition is called bacterial pneumonia.[25]
S. pneumoniae undergoes spontaneous phase variation, changing between transparent and opaque colony phenotypes. The transparent phenotype has a thinner capsule and expresses large amounts of phosphorylcholine (ChoP) and choline-binding protein A (CbpA), contributing to the bacteria's ability to adhere and colonize in the nasopharynx.[26] The opaque phenotype is characterized by a thicker capsule, resulting in increased resistance to host clearance.[26] It expresses large amounts of capsule and pneumococcal surface protein A (PspA) which help the bacteria survive in the blood.[27] Phase-variation between these two phenotypes allows S. pneumoniae to survive in different human body systems.
Diseases and symptoms
Pneumonia is the most prevalent disease caused by Streptococcus pneumoniae. Pneumonia is a lung infection characterized by symptoms such as fever, chills, coughing, rapid or labored breathing, and chest pain.[28] For the elderly, those who contract pneumonia have also shown these lesser nonspecific symptoms, but also tend to show that they have tachypnea a few days before clinical certainty that they have contracted the bacterial illness. Tachypnea is characterized by rapid and shallow breathing and can affect a person’s ability to sleep, chest pain, and a decreased appetite.[29]
While a few different bacterial infections can lead to meningitis, S. pneumoniae is one of the leading causes of this infection. Pneumococcal meningitis occurs when the bacteria goes from the blood to the central nervous system, which is made up of the brain and the spinal cord. Here, the infection will spread and cause inflammation, leading to severe disabilities like brain damage or hearing loss or limb removal or death.[30] Symptoms include common problems such as head aches, fevers, and nausea, but the more telling signs that a bacterial infection may have reached the brain are sensitivity to light, seizures, having limited range in neck movement, and easy bruising all over the body.
Osteomyelitis, or bone infection, is a rare occurrence but has been seen in patients who were diagnosed to have a S. pneumoniae infection that went untreated for too long.[31]
Sepsis is caused by overwhelming response to an infection and leads to tissue damage, organ failure, and even death. The symptoms include confusion, shortness of breath, elevated heart rate, pain or discomfort, over-perspiration, fever, shivering, or feeling cold.[32][33]
Less severe illnesses that can be caused by pneumococcal infection are conjunctivitis (pink eye ), otitis media (middle ear infection), Bronchitis (airway inflammation), and sinusitis (sinus infection).[34]
Vaccine
Due to the importance of disease caused by S. pneumoniae, several vaccines have been developed to protect against invasive infection. The World Health Organization recommends routine childhood pneumococcal vaccination;[35] it is incorporated into the childhood immunization schedule in a number of countries including the United Kingdom,[36] the United States,[37] Greece,[38]and South Africa.[39]
Currently, there are two vaccines available for S. pneumoniae: the pneumococcal polysaccharide vaccine (PPV23) and the pneumococcal conjugate vaccine (PCV13). PPV23 functions by utilizing CPS to stimulate the production of type-specific antibodies, initiating processes such as complement activation, opsonization, and phagocytosis to combat bacterial infections. It elicits a humoral immune response targeting the CPS present on the bacterial surface.[40] PPSV23 offers T-cell-independent immunity and requires revaccination 5 years after the first vaccination because of its temporary nature.[41] PCV13 was developed when determining its low efficacy in children and infants. PCV13 elicits a T-cell-dependent response and provides enduring immunity by promoting interaction between B and T cells, leading to an enhanced and prolonged immune response.[41]
Biotechnology
Components from S. pneumoniae have been harnessed for a range of applications in biotechnology. Through engineering of surface molecules from this bacterium, proteins can be irreversibly linked using the sortase enzyme[42] or using the SnoopTag/SnoopCatcher reaction.[43] Various glycoside hydrolases have also been cloned from S. pneumoniae to help analysis of cell glycosylation.[44]
Interaction with Haemophilus influenzae
Historically, Haemophilus influenzae has been a significant cause of infection, and both H. influenzae and S. pneumoniae can be found in the human upper respiratory system. A study of competition in vitro revealed S. pneumoniae overpowered H. influenzae by attacking it with hydrogen peroxide.[45] There is also evidence that S. pneumoniae uses hydrogen peroxide as a virulence factor.[46] However, in a study adding both bacteria to the nasal cavity of a mouse within two weeks, only H. influenzae survives; further analysis showed that neutrophils (a type of phagocyte) exposed to dead H. influenzae were more aggressive in attacking S. pneumoniae.[47]
Diagnosis


Diagnosis is generally made based on clinical suspicion along with a positive culture from a sample from virtually any place in the body. S. pneumoniae is, in general, optochin sensitive, although optochin resistance has been observed.[48]
The recent advances in next-generation sequencing and comparative genomics have enabled the development of robust and reliable molecular methods for the detection and identification of S. pneumoniae. For instance, the Xisco gene was recently described as a biomarker for PCR-based detection of S. pneumoniae and differentiation from closely related species.[49]
Atromentin and leucomelone possess antibacterial activity, inhibiting the enzyme enoyl-acyl carrier protein reductase, (essential for the biosynthesis of fatty acids) in S. pneumoniae.[50]
Resistance
Resistant pneumococcal strains are called penicillin-resistant pneumococci (PRP),[51] penicillin-resistant Streptococcus pneumoniae (PRSP),[52] Streptococcus pneumoniae penicillin resistant (SPPR)[53] or drug-resistant Strepotococcus pneumoniae (DRSP). In 2015, in the US, there were an estimated 30,000 cases, and in 30% of them the strains were resistant to one or more antibiotics.[54]
See also
References
- ↑ Ryan KJ, Ray CG, eds. (2004). Sherris Medical Microbiology. McGraw Hill. ISBN 978-0-8385-8529-0.
- ↑ "Streptococcus pneumoniae". microbewiki.kenyon.edu. Retrieved 2017-10-24.
- ↑ "Transmission". cdc.org. Retrieved 24 Oct 2017.
- ↑ Baucells B, Mercadal Hally M, Álvarez Sánchez A, Figueras Aloy J (2015). "Asociaciones de probióticos para la prevención de la enterocolitis necrosante y la reducción de la sepsis tardía y la mortalidad neonatal en recién nacidos pretérmino de menos de 1.500g: una revisión sistemática". Anales de Pediatría. 85 (5): 247–255. doi:10.1016/j.anpedi.2015.07.038. ISSN 1695-4033. PMID 26611880.
- ↑ van de Beek D, de Gans J, Tunkel AR, Wijdicks EF (5 January 2006). "Community-Acquired Bacterial Meningitis in Adults". New England Journal of Medicine. 354 (1): 44–53. doi:10.1056/NEJMra052116. ISSN 0028-4793. PMID 16394301.
- ↑ Siemieniuk RA, Gregson, Dan B., Gill, M. John (Nov 2011). "The persisting burden of invasive pneumococcal disease in HIV patients: an observational cohort study". BMC Infectious Diseases. 11: 314. doi:10.1186/1471-2334-11-314. PMC 3226630. PMID 22078162.
- ↑ Paton JC, Trappetti C (2019-04-12). Fischetti VA, Novick RP, Ferretti JJ, Portnoy DA, Braunstein M, Rood JI (eds.). "Streptococcus pneumoniae Capsular Polysaccharide". Microbiology Spectrum. 7 (2). doi:10.1128/microbiolspec.GPP3-0019-2018. ISSN 2165-0497. PMC 11590643. PMID 30977464.
- ↑ Morais V, Dee V, Suárez N (2018-10-12). "Purification of Capsular Polysaccharides of Streptococcus pneumoniae: Traditional and New Methods". Frontiers in Bioengineering and Biotechnology. 6: 145. doi:10.3389/fbioe.2018.00145. ISSN 2296-4185. PMC 6194195. PMID 30370268.
- ↑ Dion CF, Ashurst JV (2024), "Streptococcus pneumoniae", StatPearls, Treasure Island (FL): StatPearls Publishing, PMID 29261971, retrieved 2024-04-15
- 1 2 Plotkin S, Orenstein W, Offit PA (September 22, 2012). Vaccines. Elsevier – Saunders. p. 542. ISBN 978-1-4557-0090-5. Retrieved July 2, 2015.
- ↑ Sternberg GM (30 April 1881). "A fatal form of septicaemia in the rabbit produced by the subcutaneous injection of human saliva. An experimental research". Bulletin of the National Board of Health..
- ↑ Pasteur L (1881). "Sur une maladie nouvelle provoquée par la salive d'un enfant mort de rage". Comptes Rendus de l'Académie des Sciences de Paris. 92: 159..
- ↑ Winslow, C., J. Broadhurst (1920). "The Families and Genera of the Bacteria: Final Report of the Committee of the Society of American Bacteriologists on Characterization and Classification of Bacterial Types". J Bacteriol. 5 (3): 191–229. doi:10.1128/JB.5.3.191-229.1920. PMC 378870. PMID 16558872.
- ↑ Wainer H (2014). Medical Illuminations: Using Evidence, Visualization and Statistical Thinking to Improve Healthcare. Oxford University Press. p. 53. ISBN 978-0-19-966879-3. Retrieved July 4, 2015.
- ↑ Griffith F (January 1928). "The Significance of Pneumococcal Types". Journal of Hygiene. 27 (2): 113–159. doi:10.1017/S0022172400031879. PMC 2167760. PMID 20474956.
- ↑ Avery OT, MacLeod CM, McCarty M (1944). "Studies on the chemical nature of the substance inducing transformation of pneumococcal types: induction of transformation by a desoxyribonucleic acid fraction isolated from pneumococcus type III". J Exp Med. 79 (2): 137–158. doi:10.1084/jem.79.2.137. PMC 2135445. PMID 19871359.
- ↑ Lederberg J (1994). "The Transformation of Genetics by DNA: An Anniversary Celebration of Avery, Macleod and Mccarty (1944)". Genetics. 136 (2): 423–6. doi:10.1093/genetics/136.2.423. PMC 1205797. PMID 8150273.
- ↑ van der Poll T, Opal SM (2009). "Pathogenesis, treatment, and prevention of pneumococcal pneumonia". Lancet. 374 (9700): 1543–56. doi:10.1016/S0140-6736(09)61114-4. PMID 19880020. S2CID 28676845.
- ↑ Rezaei Javan R, Van Tonder A, King J, Harrold C, Brueggemann A (August 2018). "Genome Sequencing Reveals a Large and Diverse Repertoire of Antimicrobial Peptides". Frontiers in Microbiology. 2012 (9): 2012. doi:10.3389/fmicb.2018.02012. PMC 6120550. PMID 30210481.
- ↑ Bernstein H, Bernstein C, Michod RE. Sex in microbial pathogens. Infect Genet Evol. 2018 Jan;57:8-25. doi: 10.1016/j.meegid.2017.10.024. Epub 2017 Oct 27. PMID 29111273
- ↑ Claverys JP, Prudhomme M, Martin B (2006). "Induction of competence regulons as a general response to stress in gram-positive bacteria". Annu. Rev. Microbiol. 60: 451–75. doi:10.1146/annurev.micro.60.080805.142139. PMID 16771651.
- ↑ Engelmoer DJ, Rozen DE (December 2011). "Competence increases survival during stress in Streptococcus pneumoniae". Evolution. 65 (12): 3475–85. doi:10.1111/j.1558-5646.2011.01402.x. PMID 22133219. S2CID 24634666.
- ↑ Michod RE, Bernstein H, Nedelcu AM (May 2008). "Adaptive value of sex in microbial pathogens" (PDF). Infect. Genet. Evol. 8 (3): 267–85. Bibcode:2008InfGE...8..267M. doi:10.1016/j.meegid.2008.01.002. PMID 18295550.
- ↑ Li G, Liang Z, Wang X, Yang Y, Shao Z, Li M, Ma Y, Qu F, Morrison DA, Zhang JR (2016). "Addiction of Hypertransformable Pneumococcal Isolates to Natural Transformation for In Vivo Fitness and Virulence". Infect. Immun. 84 (6): 1887–901. doi:10.1128/IAI.00097-16. PMC 4907133. PMID 27068094.
- ↑ Anderson C. "Pathogenic Properties (Virulence Factors) of Some Common Pathogens" (PDF).
- 1 2 Wang J, Li JW, Li J, Huang Y, Wang S, Zhang JR (2020-03-18). Wessels MR (ed.). "Regulation of pneumococcal epigenetic and colony phases by multiple two-component regulatory systems". PLOS Pathogens. 16 (3): e1008417. doi:10.1371/journal.ppat.1008417. ISSN 1553-7374. PMC 7105139. PMID 32187228.
- ↑ Loughran AJ, Orihuela CJ, Tuomanen EI (2019-04-12). Fischetti VA, Novick RP, Ferretti JJ, Portnoy DA, Braunstein M, Rood JI (eds.). "Streptococcus pneumoniae : Invasion and Inflammation". Microbiology Spectrum. 7 (2). doi:10.1128/microbiolspec.GPP3-0004-2018. ISSN 2165-0497. PMC 6422050. PMID 30873934.
- ↑ Lim WS (2022), "Pneumonia—Overview", Encyclopedia of Respiratory Medicine, Elsevier, pp. 185–197, doi:10.1016/b978-0-12-801238-3.11636-8, ISBN 978-0-08-102724-0, retrieved 2024-12-05
- ↑ Zalacain R, Torres A (July 2004). "Pneumonia in the Elderly". Clinical Pulmonary Medicine. 11 (4): 210–218. doi:10.1097/01.cpm.0000132888.49928.86. ISSN 1068-0640.
- ↑ Gil E, Wall E, Noursadeghi M, Brown JS (2023-01-04). "Streptococcus pneumoniae meningitis and the CNS barriers". Frontiers in Cellular and Infection Microbiology. 12. doi:10.3389/fcimb.2022.1106596. ISSN 2235-2988.
- ↑ Sheybani F, Figueiredo AH, Brouwer MC, van de Beek D (October 2021). "Vertebral osteomyelitis in bacterial meningitis patients". International Journal of Infectious Diseases. 111: 354–359. doi:10.1016/j.ijid.2021.08.069. ISSN 1201-9712. PMID 34487853.
- ↑ "Symptoms and Complications". Centers for Disease Control and Prevention. 24 July 2023.
- ↑ "Pneumonia after coronavirus". KDL. 21 October 2024.
- ↑ https://my.clevelandclinic.org/health/diseases/24231-pneumococcal-disease. Retrieved December 3, 2024.
{{cite web}}: Missing or empty|title=(help) - ↑ "Pneumococcal vaccines WHO position paper--2012" (PDF). Wkly Epidemiol Rec. 87 (14): 129–44. Apr 6, 2012. PMID 24340399.
- ↑ "Children to be given new vaccine". BBC News. 8 February 2006.
- ↑ "Pneumococcal Vaccination: Information for Health Care Providers". cdc.org. Archived from the original on 23 July 2016. Retrieved 26 July 2016.
- ↑ "Greek Ministry of Health 2023 Immunisation schedule for children and adolescents". Retrieved 16 July 2024.
- ↑ "Critical decline in pneumococcal disease and antibiotic resistance in South Africa". NICD. Retrieved 20 July 2015.
- ↑ Aliberti S, Mantero M, Mirsaeidi M, Blasi F (May 2014). "The role of vaccination in preventing pneumococcal disease in adults". Clinical Microbiology and Infection. 20 (5): 52–58. doi:10.1111/1469-0691.12518. PMC 4473770. PMID 24410778.
- 1 2 Brooks LR, Mias GI (2018-06-22). "Streptococcus pneumoniae's Virulence and Host Immunity: Aging, Diagnostics, and Prevention". Frontiers in Immunology. 9: 1366. doi:10.3389/fimmu.2018.01366. ISSN 1664-3224. PMC 6023974. PMID 29988379.
- ↑ Nikghalb, Kevyan D. (2018). "Expanding the Scope of Sortase-Mediated Ligations by Using Sortase Homologues". ChemBioChem. 19 (7): 185–195. doi:10.1002/cbic.201700517. PMID 29124839. S2CID 23874288.
- ↑ Veggiani, Gianluca (2014). "Programmable polyproteams built using twin peptide superglues". PNAS. 113 (5): 1202–1207. Bibcode:2016PNAS..113.1202V. doi:10.1073/pnas.1519214113. PMC 4747704. PMID 26787909.
- ↑ Gregg, Katie J (16 October 2015). "Structural Analysis of a Family 101 Glycoside Hydrolase in Complex with Carbohydrates Reveals Insights into Its Mechanism". Journal of Biological Chemistry. 290 (42): 25657–69. doi:10.1074/jbc.M115.680470. PMC 4646209. PMID 26304114.
- ↑ Pericone, Christopher D., Overweg, Karin, Hermans, Peter W. M., Weiser, Jeffrey N. (2000). "Inhibitory and Bactericidal Effects of Hydrogen Peroxide Production by Streptococcus pneumoniae on Other Inhabitants of the Upper Respiratory Tract". Infect Immun. 68 (7): 3990–3997. doi:10.1128/IAI.68.7.3990-3997.2000. PMC 101678. PMID 10858213.
- ↑ Mraheil, MA. (2021). "Dual Role of Hydrogen Peroxide as an Oxidant in Pneumococcal Pneumonia". Antioxid Redox Signal. 20 (34): 962–978. doi:10.1089/ars.2019.7964. PMC 8035917. PMID 32283950.
- ↑ Lysenko ES, Ratner AJ, Nelson AL, Weiser JN (2005). "The Role of Innate Immune Responses in the Outcome of Interspecies Competition for Colonization of Mucosal Surfaces". PLOS Pathog. 1 (1): e1. doi:10.1371/journal.ppat.0010001. PMC 1238736. PMID 16201010. Full text
- ↑ Pikis A, Campos JM, Rodriguez WJ, Keith JM (2001). "Optochin Resistance in Streptococcus pneumoniae: Mechanism, Significance, and Clinical Implications". The Journal of Infectious Diseases. 184 (5): 582–90. doi:10.1086/322803. ISSN 0022-1899. JSTOR 30137322. PMID 11474432.
- ↑ Salvà-Serra F, Connolly G, Moore ER, Gonzales-Siles L (2017-12-15). "Detection of "Xisco" gene for identification of Streptococcus pneumoniae isolates". Diagnostic Microbiology and Infectious Disease. 90 (4): 248–250. doi:10.1016/j.diagmicrobio.2017.12.003. ISSN 1879-0070. PMID 29329755.
- ↑ Zheng CJ, Sohn MJ, Kim WG (2006). "Atromentin and leucomelone, the first inhibitors specific to enoyl-ACP reductase (FabK) of Streptococcus pneumoniae". Journal of Antibiotics. 59 (12): 808–12. doi:10.1038/ja.2006.108. PMID 17323650.
- ↑ Nilsson P, Laurell MH (2001). "Carriage of penicillin-resistant Streptococcus pneumoniae by children in day-care centers during an intervention program in Malmo, Sweden". The Pediatric Infectious Disease Journal. 20 (12): 1144–9. doi:10.1097/00006454-200112000-00010. PMID 11740321.
- ↑ Block SL, Harrison CJ, Hedrick JA, Tyler RD, Smith RA, Keegan E, Chartrand SA (1995). "Penicillin-resistant Streptococcus pneumoniae in acute otitis media: risk factors, susceptibility patterns and antimicrobial management". The Pediatric Infectious Disease Journal. 14 (9): 751–9. doi:10.1097/00006454-199509000-00005. PMID 8559623.
- ↑ Koiuszko S, Bialucha A, Gospodarek E (2007). "The drug susceptibility of penicillin-resistant Streptococcus pneumoniae". Medycyna Doswiadczalna I Mikrobiologia. 59 (4): 293–300. PMID 18416121.
- ↑ "Drug Resistance". cdc.gov. Retrieved 17 February 2019.
External links
- GAVI Alliance Archived 2014-08-20 at the Wayback Machine
- PneumoADIP
- PATH's Vaccine Resource Library pneumococcal resources
- Centers for Disease Control and Prevention (2012). "Ch. 16: Pneumococcal Disease". In Atkinson W, Wolfe S, Hamborsky J (eds.). Epidemiology and Prevention of Vaccine-Preventable Diseases (12th ed.). Washington DC: Public Health Foundation. pp. 233–248. Archived from the original on 2017-03-10.
- Type strain of Streptococcus pneumoniae at BacDive - the Bacterial Diversity Metadatabase Archived 2020-04-20 at the Wayback Machine
